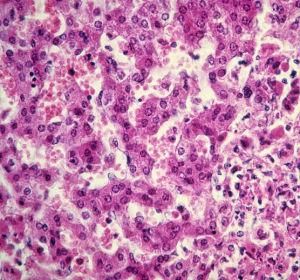
單純皰疹

病因
人類HSV系DNA類病毒,根據其抗原性質的不同分為兩個亞型:即HSV-Ⅰ和HSV-Ⅱ。HSV-Ⅰ主要侵犯面、腦及腰以上部位,HSV-Ⅱ主要侵犯生殖器及腰以下部位。正常人可作為病毒攜帶者。人是單純皰疹病毒惟一的自然宿主,70%~90%的成人皆曾感染過HSV-Ⅰ。病毒經過口腔、呼吸道、生殖器以及皮膚破損處侵入體內,潛居於人體正常黏膜、血液、唾液、神經組織及多數器官內。當某些誘發因素如發熱、受涼、日曬、情緒激動、胃腸功能紊亂、藥物過敏、過度疲勞、機械性刺激以及月經、妊娠等均促成本病發生,可經血行或神經通路播散。
臨床表現
臨床上可分為原髮型與復髮型兩型。初發單純皰疹潛伏期2~12天,平均6天,幾乎所有的內臟或黏膜表皮部位都可分離到HSV。初次感染(不論是HSV-Ⅰ或是HSV-Ⅱ)時宿主急性期血清中無HSV抗體,常伴有全身症狀,且往往比復發性皰疹明顯。原髮型單純皰疹皮膚黏膜損害常需2~3周癒合,而復髮型單純皰疹的皮損大多於1周內即可消失。
1.皮膚皰疹
好發於皮膚黏膜交界處,以唇緣、口角、鼻孔周圍等處多見。初起局部皮膚發癢、灼熱或刺痛,進而充血、紅暈,後出現針頭或米粒大小簇集水皰群,基底微紅,水皰彼此並不融合,但可同時出現多簇水皰群。水皰壁薄,皰液清亮,短期自行潰破、糜爛、滲液,2~10天后乾燥結痂,脫痂後不留瘢痕。
2.口腔皰疹
皰疹和潰瘍出現在口腔黏膜、舌部、齒齦、咽部,可波及食管。患者局部疼痛、拒食、流涎。可伴發熱及頜下淋巴結和(或)頸淋巴結腫大。兒童與青年人多見。
3.生殖器皰疹
主要為HSV-Ⅱ型感染所致。生殖器、會陰、外陰周圍、股部和臀部皮膚均可受累,出現皰疹、潰瘍及點片狀糜爛。男性多發生在龜頭、包皮、冠狀溝、陰莖,亦可累及陰囊;女性則多見於大小陰唇、陰蒂、陰道、宮頸,亦可累及尿道。有肛交史同性戀者可引發皰疹性直腸炎,繼而出現肛周和直腸化膿性感染或腹股溝淋巴結炎。
4.眼皰疹
表現為單皰性角膜炎、結膜炎,大多為單側性,常伴患側眼瞼皰疹或水腫及耳前淋巴結腫大。反覆發作者可致角膜潰瘍、渾濁,甚至穿孔致盲。在新生兒和AIDS患者中,可發生脈絡膜視網膜炎。
5.皰疹性瘰疽
是原發口或生殖器皰疹的一種併發症。病毒可經手指上皮破損處進入或由於職業及其他原因而直接進入手指表皮內,皰疹病變常發生於末端指節,深入至甲床形成蜂窩狀壞死;故局部疼痛劇烈,呈跳痛樣,常伴有發熱、肘窩和腋窩淋巴結炎。經常裸手接觸皰疹患者的牙醫和護士易有罹患本病的危險。
6.皰疹性濕疹
系原由慢性濕疹、皮炎等病損的患者合併HSV感染所致,易誤診為原有濕疹的加重。在皮損區及其周圍皮膚突然發生病毒感染,或發生血行播散,累及其他重要臟器而致病情進一步惡化。
7.新生兒皰疹
新生兒HSV感染中的70%由HSV-Ⅱ所致,皆因出生時接觸生殖道分泌物而被感染;先天性感染常是原發性HSV感染的母親在妊娠期導致胎兒宮內感染。宮內感染的胎兒可早產,或先天畸形,或智力發育障礙,即所謂“TQRCH”綜合徵。新生兒感染HSV後可呈現無症狀隱性感染,也可引起不同形式或不同程度的臨床表現。輕者僅為口腔、皮膚、眼部皰疹,重者則呈中樞神經系統感染甚至全身播散性感染。
8.播散性單純皰疹
播散性HSV感染多發於6個月至3歲的兒童,亦可見於原發性或繼發性免疫功能低下(抑制)者。初起表現為重症皰疹性口齦炎、食管炎、或外陰陰道炎,高熱、甚至驚厥,繼而全身發生廣泛性水皰,皰頂臍凹,同時可發生病毒血症,引起皰疹性肝炎、腦炎、肺炎、胃腸炎以及腎上腺功能障礙等內臟損害。
鑑別診斷
凡體表部位具有典型皰疹損害者診斷不難。常見的單純皰疹多為復髮型,依其臨床皮損特點,發作部位即可診斷。對某些少見的原發感染者,或損害僅存在於腔道深處(如生殖道、呼吸道等),或僅有內臟皰疹損害而體表無損害者,則有可能誤診。本病有時需和面部帶狀皰疹、膿皰瘡及固定性藥疹相鑑別。
治療
體表皮膚黏膜限局性HSV感染可僅採用局部用藥治療,對症狀、皮損較重,或播散性感染或重要臟器受累的患者則應給予全身性抗病毒用藥及相應的對症支持治療。
1.局部治療
以收斂、乾燥,防止繼發感染為主。可外用3%酞丁胺霜、3%阿昔洛韋眼膏及2%甲紫溶液局部塗搽,3或4次/天即可。若有繼發感染,可用0.5%新黴素軟膏、0.5%金黴素眼膏或莫匹羅星軟膏、達維邦乳膏等。糜爛滲出時,可用3%硼酸溶液、1%醋酸鋁溶液局部濕敷,可以使皮損乾燥、疼痛減輕或消失,縮短病程。
皰疹性角膜炎結膜炎,可用0.1%皰疹淨眼藥水,1%阿昔洛韋眼藥水及0.1%病毒唑眼藥水滴眼,1次/2小時。復發性患者,可用3%阿昔洛韋眼膏與0.1%地塞米松滴眼液聯合治療,較單用抗病毒藥物見效快、療效高、療程短。
2.全身治療
可選擇核苷類抗病毒藥物口服治療。除核苷類抗病毒藥物外,非核苷類抗病毒藥亦可選用,如利巴韋林、異丙肌苷、聚肌胞、干擾素等,可與核苷類藥物配合使用。
預防
1.新生兒及免疫功能低下者、燙傷和濕疹患者,應儘可能避免接觸HSV感染者。
2.對患有生殖器皰疹的產婦,宜行剖腹產,以避免胎兒分娩時感染。
3.安全套可減少生殖器皰疹的傳播,尤其是在無症狀排毒期。一旦出現皰疹皮損,即應避免性生活。
4.嚴禁口對口餵飼嬰兒。
5.可選用HSV疫苗進行預防接種。